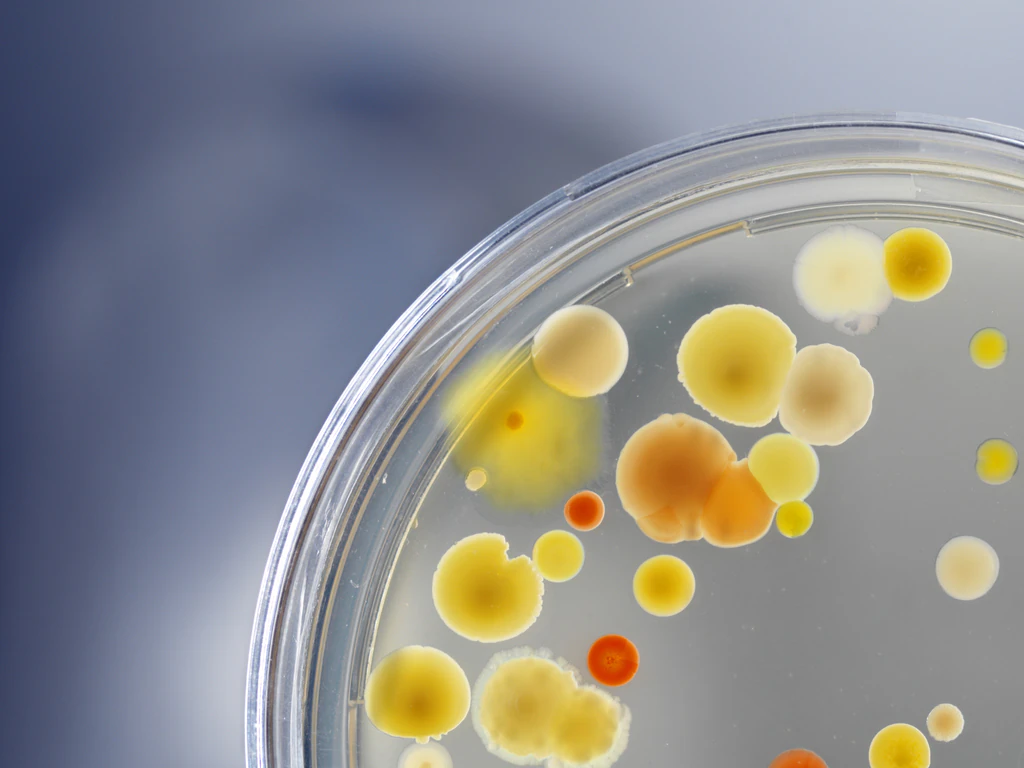
'Mysterious bacteria' with 'unique abilities' is found living on Chinese space station

Loading...
Lifestyle






Health
Wellness tips, fitness advice, and health related breakthroughs.
Explore
LGBTQ
Stories, pride, and voices from the LGBTQ community.
Explore
Relationships
Advice, stories, and real talk on love, dating, and more.
Explore
Travel
Destination guides, tips, and adventures from around the world.
Explore
Animals
Heartwarming tales, wild wonders, and cute companions.
Explore
Science & Tech
Innovations, discoveries, and the future of technology.
Explore








.webp_QQJmGo?tr=cr-345.0.1535.1190,f-webp,q-70)

.webp_vBqgAR?tr=cr-242.0.1293.1051,f-webp,q-70)












.webp_ke6C2y?tr=cr-169.8.1505.1344,f-webp,q-70)

.jpg_FQ4t4g?tr=f-webp,q-70)
